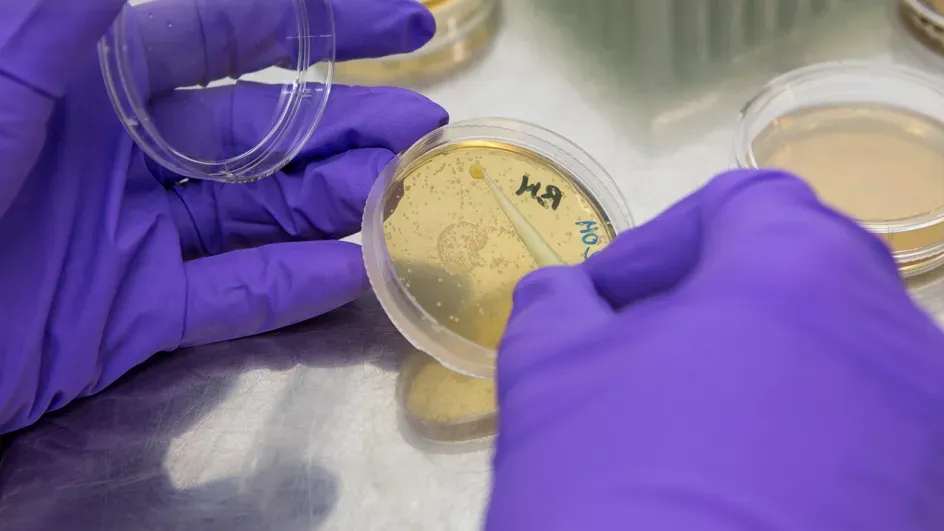

Science services
Our specialists in commercial phytochemistry, regulation of international trade in plants and medicinal plant names can provide expertise to companies, professionals or researchers.


Commercial Innovation Unit
Providing unique expertise for the authentication of botanical and fungal extracts used in industry.

CITES Scientific Authority for Flora
We provide impartial, scientific advice on The Convention on International Trade in Endangered Species (CITES).

Medicinal Plant Names Services
Enabling effective communication for global health, regulation and research.

Wood Identification
We study the chemical and physical properties of wood and provide wood identification services.
Research facilities
We have a wide range of state-of-the-art platforms, as well as a research site in Madagascar, that supports the delivery our science